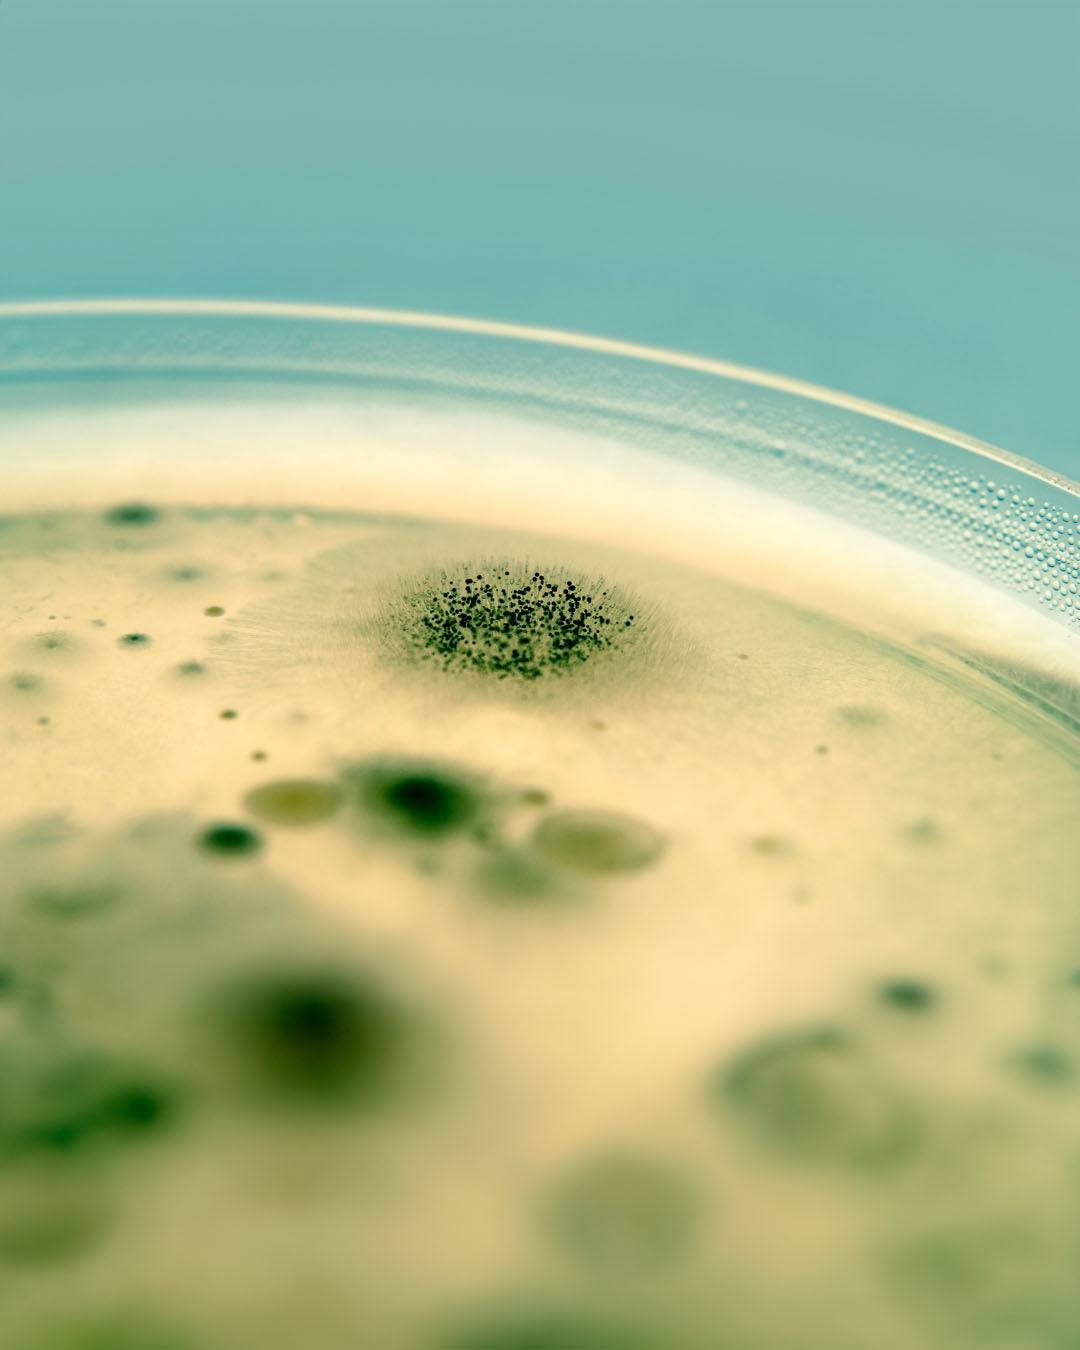
Schimmel, Cannabis, Hanf, Schimmelsporen

Cannabis Schimmel – erkennen, verhindern und effektiv bekämpfen
|
|
Lesezeit 8 min
Noch für GRATIS Versand!
Noch für GRATIS Versand!
Liquid error (sections/dbtfy-cart-goal line 68): comparison of String with 0.0 failed
|
|
Lesezeit 8 min
Schimmel auf Cannabis (Hanf) ist ein echter Spielverderber. Gerade wenn die Pflanze in der Blütephase steht und du dich schon auf eine aromatische Ernte freust, zeigt sich plötzlich ein pelziger Belag auf den Buds. Der Schock ist groß, denn ein Schimmelbefall kann deine gesamte Arbeit zunichtemachen. Ob du indoor oder im Garten anbaust – Cannabis Schimmel kann überall auftreten. Zum Glück lässt sich das Problem mit etwas Fachwissen, sorgfältiger Pflege und einem guten Blick für Details in den Griff bekommen, wie dieser Artikel eindrucksvoll aufzeigt.
HANS Brainfood begleitet dich mit hochwertigen Cannabis Samen und nachhaltigen Tipps zur Behandlung von Schimmel. Damit deine Pflanzen fit bleiben – von der Keimung bis zur Lagerung.
Schimmelpilze sind Mikroorganismen, die sich von organischem Material ernähren und es zersetzen. Für Hanfpflanzen bedeutet das: Ein Schimmelbefall greift die Struktur der Pflanze an, zerstört die Blüten und macht sie unbrauchbar.
Schimmel auf Cannabis zeigt sich oft als grauer, weißer oder gelblicher Belag auf Blättern oder Buds. Besonders gefährlich: Manche Schimmelarten breiten sich tief im Inneren dichter Cannabis Blüten aus und bleiben lange unentdeckt.
Die häufigsten Arten von Schimmel auf Cannabis Pflanzen sind Grauschimmel, Mehltau und Rußschimmel – sie alle lieben dieselben Bedingungen wie normaler Schimmel: Feuchtigkeit, mangelnde Luftzirkulation und abgestorbene Pflanzenteile.
Grauschimmel (Botrytis) : Dieser Schimmelpilz erscheint als flauschiger, grauer Belag. Er zerstört die Blütenstruktur von innen heraus.
Echter Mehltau : Ein weißlicher, pudriger Belag auf Blättern und Stängeln. Leicht mit Staub zu verwechseln.
Falscher Mehltau : Eine Schimmelart, die eher gelblich-braun daherkommt. Sitzt vor allem auf der Blattunterseite.
Diese Schimmelpilze lieben feuchte Umgebungen mit schlechter Luftzirkulation und befallen am liebsten geschwächte oder sehr dichte Cannabispflanzen.
Schimmelsporen sind allgegenwärtig – in der Luft, im Boden, auf deiner Kleidung. Solange die Bedingungen stimmen, bleiben sie harmlos. Doch wenn hohe Luftfeuchtigkeit, stehende Luft und Temperaturschwankungen aufeinandertreffen, werden die Sporen aktiv.
Besonders in der Blütephase kann sich Schimmel explosionsartig ausbreiten. Er ruiniert nicht nur die Struktur der Blüten, sondern beeinträchtigt auch Geruch und Geschmack. Wer seine Cannabis Pflanzen sicher durch den Anbau bringen will, sollte die Risiken kennen und gezielt gegensteuern.
Starte jetzt mit robusten, widerstandsfähigen Cannabis Samen in Bio-Qualität von HANS Brainfood – für einen starken Start in den Anbau!
Schimmel auf Cannabis Pflanzen entsteht nicht zufällig – er ist das Ergebnis ungünstiger Anbaubedingungen. Neben dem Mikroklima spielen auch Pflegefehler eine zentrale Rolle. In den folgenden Abschnitten erfährst du, welche Einflüsse besonders kritisch sind und wie du sie vermeiden kannst.
Die klimatische Umgebung ist einer der Hauptfaktoren für Schimmelbildung. Wenn Temperatur und Luftfeuchtigkeit nicht optimal aufeinander abgestimmt sind, entsteht schnell ein Milieu, in dem sich Schimmelsporen ausbreiten können. Diese Faktoren solltest du kontrollieren:
Hohe Luftfeuchtigkeit über 60 % begünstigt die Schimmelbildung, vor allem bei schlecht belüfteten Räumen oder regnerischem Outdoor Anbau.
Temperaturschwankungen führen zu Kondenswasser an Blättern und Buds.
Zu wenig Luftzirkulation erzeugt stehende Luft, in der sich Schimmelsporen wohlfühlen.
Nicht nur das Wetter kann Schimmel begünstigen – auch Pflegefehler und unachtsame Routinen im Umgang mit deinen Pflanzen erhöhen das Risiko. Diese Punkte solltest du im Blick behalten:
Unzureichendes Ausdünnen der Pflanze fördert dichte, feuchte Bud-Strukturen.
Minderwertige Erde oder alte, feuchte Töpfe können Sporenherde sein.
Insekten wie Trauermücken oder Blattläuse übertragen Schimmelsporen.
Reste von Wasser auf den Blättern oder stehendes Wasser im Untersetzer begünstigen die Schimmelbildung zusätzlich.
Zu dichter Pflanzabstand verhindert die Luftzirkulation zwischen den Gewächsen
Schmutzige Werkzeuge oder Hände können Sporen unbemerkt übertragen
Schimmel lässt sich nicht immer sofort mit dem bloßen Auge erkennen. Besonders in dichten Blütenstrukturen tarnt er sich gut. Diese Merkmale solltest du im Blick haben:
Ungewöhnliche Verfärbungen an Blättern oder Blüten
Weißlich-grauer oder gelblicher Belag
Matschige, faulige Stellen im Inneren der Blüte
Ein modriger Geruch, der nicht zu gesunden Cannabis Blüten passt
Vermehrtes Auftreten von Insekten
Wer seine Pflanzen täglich kontrolliert – insbesondere ab der Blüte – erkennt die Anzeichen von Schimmel frühzeitig. Besonders wichtig: auch die unteren Pflanzenteile regelmäßig inspizieren.
Trichome sind die kleinen, harzigen Kristalle auf deinen Buds. Sie glitzern im Licht, fühlen sich klebrig an und sind ein Zeichen für die Reife und Qualität deiner Cannabis Pflanze. Sie entstehen ganz natürlich und sitzen dicht auf den Blüten.
Schimmel dagegen wirkt matt, faserig, oft bräunlich oder gräulich und breitet sich meist unregelmäßig aus. Im Zweifel: schnapp dir eine Lupe, achte auf Struktur, Farbe und Geruch – und entscheide im Zweifel lieber für die Sicherheit.
Ein stabiles Mikroklima ist der größte Feind von Schimmelpilzen. Indoor kannst du Temperatur und Luftfeuchtigkeit gezielt steuern. Outdoor brauchst du etwas mehr Glück mit dem Wetter – aber auch hier lassen sich die Bedingungen verbessern.
Für ein schimmelfreies Wachstum deiner Cannabis Pflanzen ist das richtige Ambiente entscheidend. Die Temperaturen sollten konstant zwischen 20 und 24 Grad liegen – Schwankungen begünstigen die Kondensation an den Blättern und fördern somit die Schimmelbildung
Auch die Luftfeuchtigkeit spielt eine zentrale Rolle: In der Blütephase sollte sie dauerhaft unter 50 % bleiben. Noch besser ist es, wenn du ein Hygrometer einsetzt, um die Werte im Blick zu behalten. Eine stetige Luftzirkulation, etwa durch Ventilatoren, verhindert stehende Luft. Zusätzlich kann UV Licht in kontrollierten Dosen helfen, Schimmelsporen inaktiv zu machen und die Luftqualität zu verbessern.
Einige Cannabis Arten sind robuster als andere. Wer in Regionen mit hoher Luftfeuchtigkeit lebt oder im Garten growt, sollte auf schnelle, stabile Cannabis Sorten mit luftiger Blütenstruktur setzen. Autoflowering Sorten sind oft weniger anfällig für Botrytis und eignen sich besonders für Einsteiger.
Wichtig ist auch die Wahl von Samen, die bekannt dafür sind, unter feuchten Bedingungen gut zu gedeihen. Im Sortiment von HANS Brainfood findest du robuste Sorten wie „Northern Light Automatic“, „White Widow Automatic“ oder „Green Gelato Automatic“, die sich durch eine kompakte Wuchsform, kurze Blütezeiten und eine hohe Widerstandskraft gegen Schimmel auszeichnen.
Die richtige Schnitttechnik verbessert nicht nur den Ertrag, sondern schützt deine Cannabis Pflanze auch vor Schimmelbildung. Durch gezielte Rückschnitte wird die Luftzirkulation innerhalb der Aufzucht verbessert, was besonders bei hoher Luftfeuchtigkeit wichtig ist. Folgende Trainingsmethoden haben sich bewährt:
Low Stress Training (LST): Zweige werden sanft heruntergebunden, um ein gleichmäßiges Kronendach auszubilden und eine bessere Luftzirkulation zu gewährleisten.
Topping von Cannabis : Der Haupttrieb wird gekappt, um mehrere Spitzen und eine flachere, besser durchlüftete Pflanzenstruktur zu fördern.
Main-Lining: Kombination aus Topping und LST für symmetrisches Wachstum und ideale Licht- und Luftverteilung.
Defoliation (gezieltes Entblättern): Entfernt überflüssige Blätter, verbessert die Belüftung im Inneren und reduziert das Risiko feuchter Mikroklimate.
ScrOG (Screen of Green): Ein Netz unterstützt gleichmäßiges Wachstum, sorgt für eine bessere Lichtverteilung und verhindert, dass sich feuchte, schimmelfreundliche Zonen bilden.
Diese Techniken fördern eine offene Struktur und verhindern feuchte, schlecht durchlüftete Zonen im Pflanzeninneren.
Eine durchdachte Pflegeroutine kräftigt deine Cannabis Pflanzen und schützt sie zuverlässig vor Schimmel. Wichtig ist eine konstante Luftzirkulation, saubere Werkzeuge und das Entfernen welker Blätter. Auch die Feuchtigkeit im Substrat sollte stimmen – zu viel Wasser begünstigt den Pilzbefall.
Wenn das Erdreich verdichtet oder ausgelaugt ist, kannst du Cannabis umtopfen , damit die Wurzeln wieder Zugang zu frischen Nährstoffen und einer funktionierenden Drainage haben. Mit etwas Routine und Aufmerksamkeit schaffst du ein stabiles, schimmelfreundliches Umfeld – ganz ohne großen Aufwand.
Wenn deine Pflanzen trotz aller Vorsichtsmaßnahmen von Schimmel befallen werden, ist schnelles und entschlossenes Handeln gefragt. Ein frühzeitiger Eingriff kann verhindern, dass sich der Pilz ausbreitet und deine gesamte Ernte gefährdet. Die folgenden Maßnahmen helfen dir, den Schaden zu begrenzen und deine Pflanzen möglichst effektiv zu schützen.
Befallene Pflanzenteile großzügig entfernen
Alle Werkzeuge und Hände desinfizieren
Luftfeuchtigkeit senken und Luftzirkulation verbessern
Pflanzen beobachten und weitere Anzeichen kontrollieren
Entsorge befallenes Pflanzenmaterial luftdicht verpackt im Hausmüll
Räume oder Growzelt gründlich reinigen, bevor du neue Pflanzen einsetzt
Je früher du eingreifst, desto größer ist die Chance, den Rest der Ernte zu retten. Leicht befallene Bereiche solltest du umgehend und großzügig aus der Pflanze herausschneiden. Achte darauf, die betroffenen Teile niemals zu kompostieren, da sich Schimmelsporen schnell im Garten verbreiten können.
Auch die Umgebung – ob Growbox oder Balkon – sollte gründlich gesäubert und für einige Tage gut durchlüftet werden. So verhinderst du einen erneuten Ausbruch und gibst deinen Pflanzen die Chance, sich zu erholen.
Effektive Mikroorganismen (EM), Neem-Extrakt oder biologische Sprühlösungen fördern das Mikrobiom deiner Pflanze und stärken die Abwehrkräfte. Sie tragen Sorge für ein ungünstiges Umfeld für Schimmelsporen und helfen, das natürliche Gleichgewicht zu stabilisieren. Besonders im Frühstadium eines Befalls bieten sie eine schonende Ergänzung zu anderen Maßnahmen. Wichtig ist, sie regelmäßig anzuwenden.
Du willst natürlich, regional und frei von Pestiziden anbauen? Wähle deine Cannabis Samen bei HANS Brainfood – für ein sicheres Gefühl von Anfang an.
Nach der Ernte beginnt die entscheidende Phase: das Trocknen. Hänge deine Pflanzen kopfüber an einer Schnur oder einem Trockenrahmen auf – idealerweise in einem dunklen, gut belüfteten Raum mit 18 bis 22 Grad und einer Luftfeuchtigkeit unter 55 %. Wichtig ist ein gleichmäßiger Luftaustausch, ohne Zugluft oder Ventilatoren, die direkt auf die Buds gerichtet sind.
Nach etwa sieben bis zehn Tagen beginnt das sogenannte Curing. Die vollständig getrockneten Buds kommen in luftdichte Gläser. In den ersten zwei Wochen solltest du die Gläser täglich kurz öffnen, damit überschüssige Feuchtigkeit entweichen kann. So reifen die Blüten schonend nach – und du beugst Schimmel zuverlässig vor.
Praktische Erfahrungen helfen oft mehr als jede Theorie. Die folgenden Aussagen zeigen, wie andere Cannabis Grower mit Schimmel umgegangen sind:
„Ich hatte einmal einen leichten Schimmelbefall. Seitdem achte ich penibel auf die Luftfeuchtigkeit und nutze ein Hygrometer.“
– Jens, Outdoor Grower aus der Pfalz
„Mir ist bei meinem ersten Indoor-Grow die komplette Ernte durch Botrytis kaputtgegangen. Heute setze ich auf Autoflower Sorten und lüfte deutlich konsequenter.“
– Sabine, Balkon Growerin in Berlin
„Ich dachte, meine Buds wären sicher – bis ich beim Curing diesen modrigen Geruch bemerkt habe.“
– Lukas, Hobbygärtner aus dem Allgäu
Schimmel wirft oft mehr Fragen auf, als du denkst – gerade, wenn man zum ersten Mal mit dem Thema in Berührung kommt. Hier findest du kompakte Antworten auf die häufigsten Unsicherheiten beim Umgang mit Schimmel auf Cannabis Pflanzen.
Nein, betroffene Pflanzenteile sollten aus Sicherheitsgründen sofort entsorgt werden.
Das hängt stark von den Bedingungen ab – bei hoher Luftfeuchtigkeit ist der Befall frühzeitig zu erkennen und die Identifizierung kann schon innerhalb weniger Stunden erfolgen.
Feuchte Buds in Gläsern können schnell schimmeln – achte daher auf gründliche Trocknung vor dem Einlagern.
Die Bekämpfung von Schimmel ist beim Cannabis Anbau ein ärgerliches, aber vermeidbares Problem, das mit etwas Mühe vermieden werden kann. Mit einem geschulten Blick, stabilen Bedingungen und etwas Erfahrung lässt sich der Pilz in Schach halten. Achte auf das Mikroklima, pflege deine Pflanzen sorgfältig und wähle stabile Genetiken. Kontrolliere Temperatur und Luftfeuchtigkeit täglich, besonders in der Blütephase. So steht einer erfolgreichen, nachhaltigen Ernte nichts mehr im Weg.
Zufrieden oder Geld zurück. So überzeugt sind wir von unseren Produkten!
Aus Liebe zur Umwelt. Versandkostenfrei ab 59€. Mit DHL & DPD.


